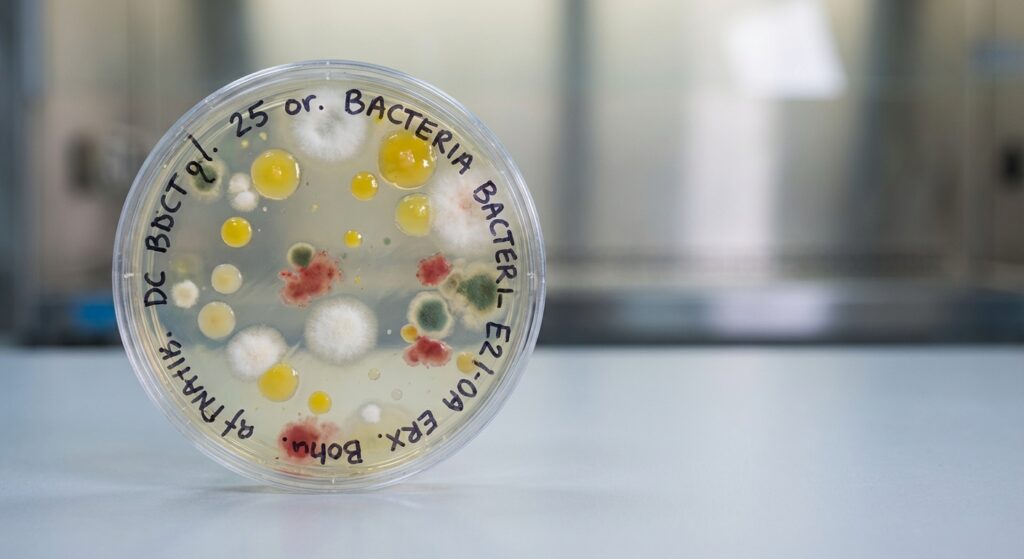
Bakterijų kolonijos biologinių įrenginių pavyzdyje

Kodėl bakterijos biologiniams įrenginiams yra tokios svarbios?
Biologiniai nuotekų valymo įrenginiai neatsiejami nuo bakterijų – šios mikroorganizmo rūšys yra pagrindiniai valymo proceso varikliai.
Bakterijos biologiniams įrenginiams kodėl jos būtinos – tai klausimas, į kurį atsakymą rasite šiame straipsnyje. Sužinosite, kokią funkciją atlieka bakterijos, kokios jų rūšys efektyviausios ir kaip išlaikyti tinkamą bakterijų balansą jūsų valymo sistemoje.
Kas yra biologiniai nuotekų valymo įrenginiai?
Biologiniai nuotekų valymo įrenginiai – tai sistemų kompleksas, skirtas efektyviai apdoroti buityje arba pramonėje susidarančias nuotekas, panaudojant natūralius mikroorganizmus, ypač bakterijas.
- Veikimo principas trumpai: nuotekos patenka į įrenginį, kur bakterijos suskaido organines medžiagas ir toksinus, tokiu būdu išvalydamos vandenį.
- Pagrindiniai sistemos komponentai: skaidymo kameros, aeravimo vienetai, dumblo kaupimo talpos ir filtravimo moduliai.
- Procesas pagrįstas natūraliais biocheminiais procesais, vykstančiais bakterijų dėka.
- Įrenginiai yra draugiški aplinkai ir gali būti pritaikyti tiek mažoms, tiek didelėms bendruomenėms.
Koks yra bakterijų vaidmuo šiuose įrenginiuose?
Bakterijos atlieka pagrindines funkcijas valant nuotekas biologiniuose įrenginiuose. Jos leidžia natūraliai ir efektyviai suskaidyti teršalus bei skatinti ekosistemų stabilumą.
- Organinių medžiagų skaidymas: bakterijos naikina organines atliekas, sumažindamos teršalų kiekį.
- Azoto ir fosforo šalinimas: tam tikros bakterijos transformuoja azotą ir fosforą į nekenksmingas formas, taip apsaugodamos aplinką nuo eutrofikacijos.
- Dumblo formavimasis ir mažinimas: bakterijos prisideda prie dumblo susidarymo, kuris yra būtinas biologiniam valymui, bet taip pat svarbu reguliuoti dumblo kiekį.
Pagrindinės bakterijų rūšys naudojamos valymo procese
Valymo procesui reikalingos įvairios bakterijų rūšys, kurios skirtingai prisideda prie nuotekų apdorojimo.
- Aerobiniai mikroorganizmai – naudoja deguonį organinių atliekų skaidymui.
- Anaerobiniai – veikia be deguonies, ypač svarbūs dumblo ir dujų susidarymo procesuose.
Kaip užtikrinti tinkamą bakterijų balansą sistemoje?
Bakterijų ekosistemos palaikymas reikalauja dėmesio ir tinkamos priežiūros.
- Reguliarus aktyvatorių naudojimas: bakterijų papildai ar aktyvatoriai padeda palaikyti bakterijų aktyvumą.
- Ko negalima pilti į kanalizaciją: cheminiai valikliai, riebalai ir antibiotikai gali sunaikinti naudingas bakterijas.
- Temperatūros ir pH lygio įtaka: optimalios sąlygos užtikrina bakterijų efektyvų darbą.
Dažniausios problemos ir jų sprendimo būdai
Šiuose įrenginiuose dažnai pasitaiko problemų, kurias galima spręsti atidžiau prižiūrint bakterijų ekosistemą ir tinkamai valant sistemą.
Nemalonus kvapas, prastas nuotekų išvalymas ar sistemos užsikimšimas gali būti ženklai, kad bakterijų pusiausvyra sutrikusi. Tinkamas priežiūros režimas ir papildomos bakterijos gali padėti išvengti šių problemų.
DUK
Kodėl bakterijos yra būtinos biologiniuose įrenginiuose?
Jos suskaido organines medžiagas ir padeda išvalyti nuotekas ekologiškai bei efektyviai.
Kaip dažnai reikia papildyti bakterijas valymo sistemoje?
Dažnumas priklauso nuo įrenginio tipo ir naudotojų įpročių, tačiau įprastai rekomenduojama kartą per kelis mėnesius.
Ar galima naudoti cheminius valiklius biologiniuose įrenginiuose?
Ne, cheminiai valikliai gali sunaikinti naudingas bakterijas ir sutrikdyti valymo procesą.
Kada ir kodėl verta rinktis papildomas bakterijas?
Papildomos bakterijos naudotos, kai natūralus mikroorganizmų kiekis sumažėja dėl ekstremalių sąlygų, pavyzdžiui, žemos temperatūros ar per didelio teršalų kiekio. Tai padeda greitai atkurti efektyvų valymo procesą ir užtikrinti sistemų ilgaamžiškumą.
Norint išsamiau sužinoti apie bakterijų svarbą, rekomenduojame apsilankyti Wikipedia puslapyje apie bakterijas ir Septikas.lt valymo įrangos kataloge.